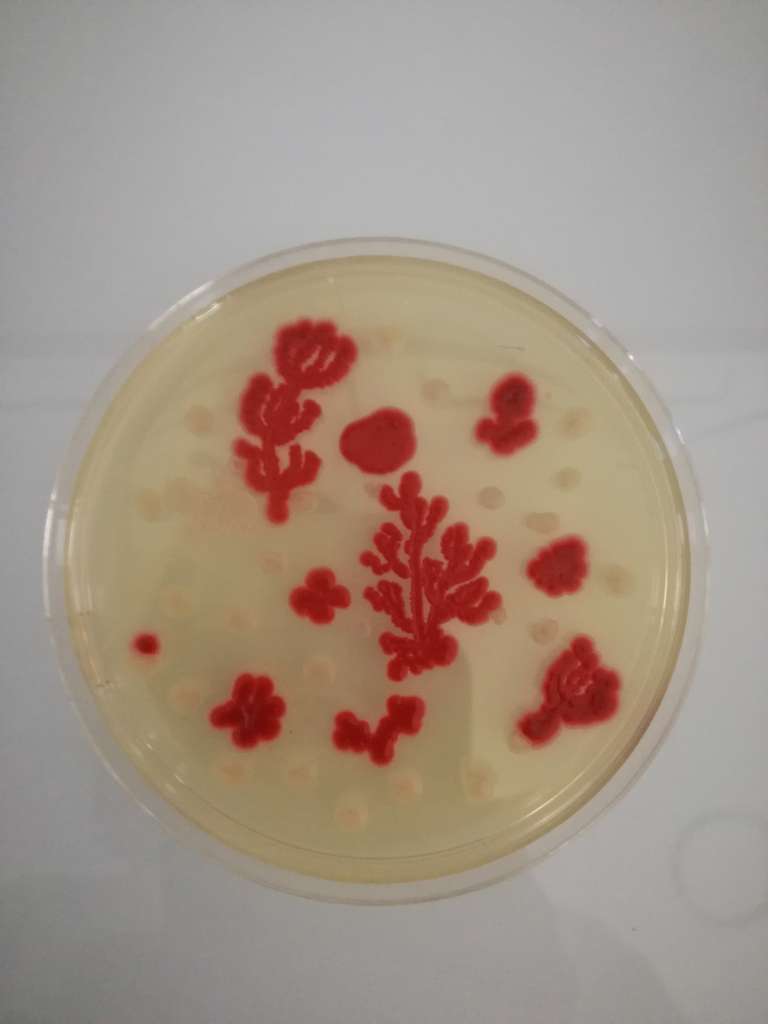

L’agar-art consiste à mettre en culture des bactéries sur milieu gélosé, tout en élaborant une production artistique.
En fonction de la composition des milieux de culture et des souches bactériennes utilisées, on obtient, après incubation 24h à 37°C, des colonies bactériennes de différentes couleurs.